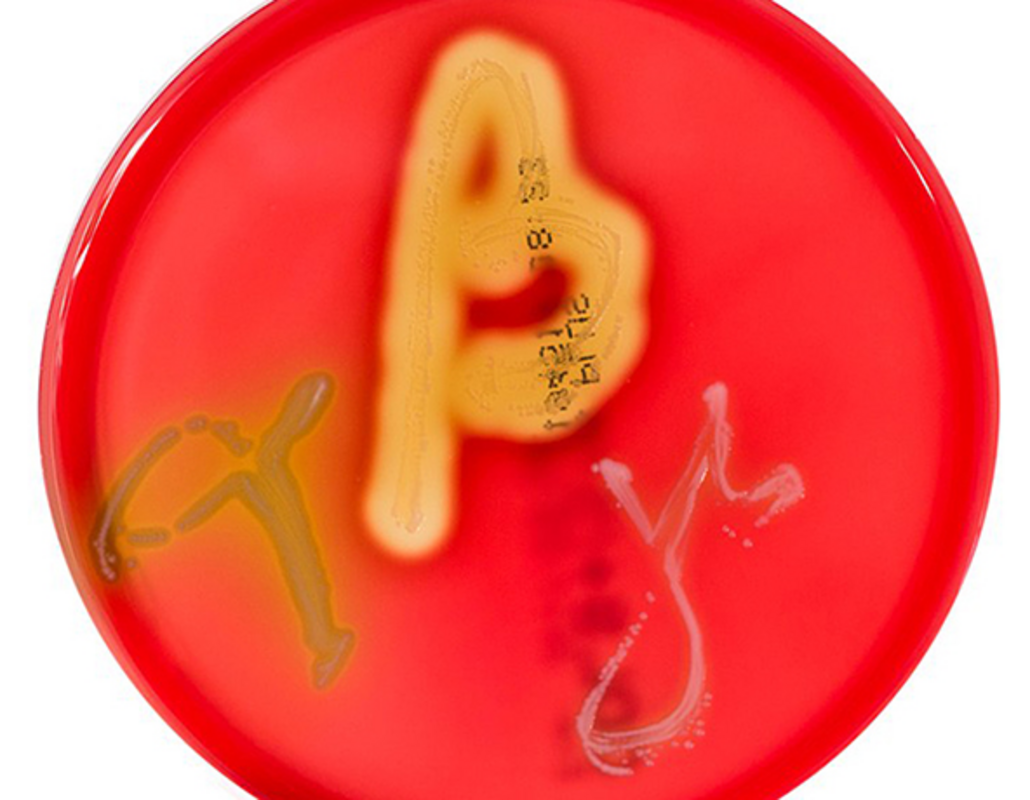
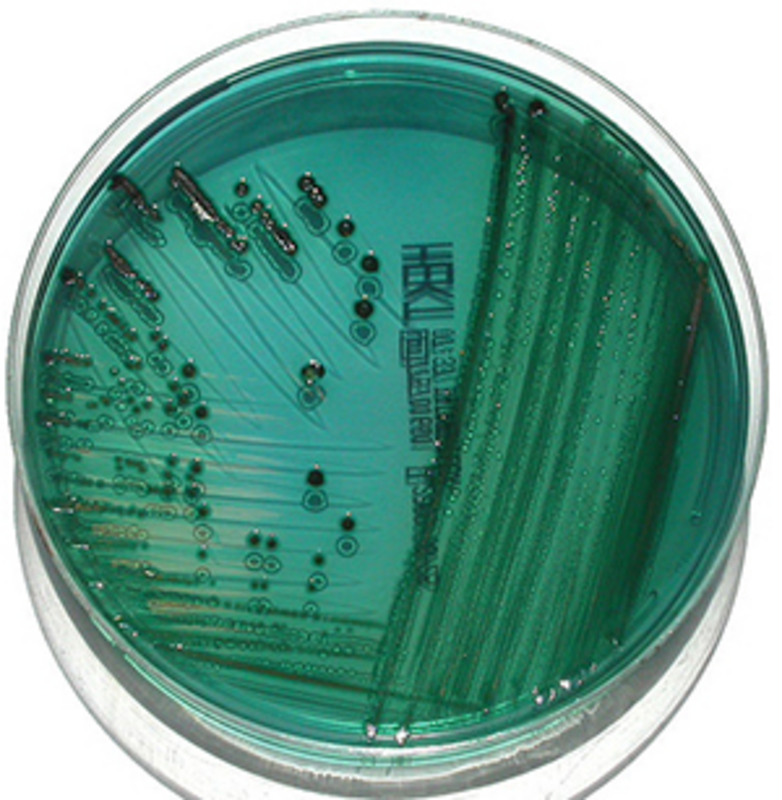

Дифференциальные среды позволяют расти нескольким различным типам бактерий, но также содержат соединения, позволяющие визуально различать роды (или даже виды) микроорганизмов.
Организмы взаимодействуют с добавленными соединениями (например, кровью, сахарами) таким образом, что визуально выделяют их среди других видов бактерий на чашке. Это позволяет быстро идентифицировать интересующие организмы, что особенно важно для сильно смешанных культур, например, из кала.
Базовый твердый агар или жидкий бульон также могут быть обогащены различными соединениями, специфичными для потребностей интересующего организма (например, аминокислотами, витаминами, гормонами). Селективные среды используются для селекции роста определенного "избранного" микроорганизма. Например, если определенный микроб резистентен к определенному антибиотику (например, новобиоцину), то этот антибиотик может быть добавлен в среду, чтобы предотвратить рост других организмов, которые не резистентны. Аналогичным образом, в среду могут быть добавлены другие химические вещества для создания селективной среды. Например, среда с NaCl способствует селекции галофилов (любителей соли) по сравнению с негалофилами.
Одно из самых мощных применений этих типов сред - объединение селективных и дифференциальных характеристик в одном типе среды. Например, солевой агар с маннитом используется для отбора галофилов (например, стафилококков), одновременно визуально различая виды стафилококков на основе ферментации маннита (S. aureus) или неспособности ферментировать маннит (S. epidermidis).

S. aureus образует желтые колонии на солевом агаре с маннитом. Обратите внимание на рост прозрачных колоний, не ферментирующих маннит. Фото: commons.wikimedia.org
Кейсы по микробиологии с использованием дифференциальных и селективных сред
Пример 1
Пациент 28 лет поступил в отделение неотложной помощи с жалобами на покраснение и боль в месте хирургического разреза на ноге. У пациента высокая температура, а из места рассечения вытекает гной. Пациенту назначается хирургическая обработка раны, и во время процедуры отбирается образец ткани, который отправляется в микробиологическую лабораторию для культивирования. Образец высевают на стандартные микробиологические среды, включая кровяной агар ( триптиказо-соевый агар, обогащенный 5% овечьей крови). После 24 часов инкубации на чашке с кровяным агаром вырастают мелкие колонии с большой зоной бета-гемолиза.
Объяснение примера 1
Кровяной агар является дифференциальной средой, поскольку на этой среде можно наблюдать 3 различных типа гемолиза, или лизиса эритроцитов. Кровяной агар позволяет расти большинству типов бактериальных организмов, но способность каждого организма лизировать эритроциты проявляется по-разному, что дает микробиологу подсказки для его идентификации. Бета-гемолитические организмы полностью лизируют эритроциты, оставляя область полного очищения под и вокруг колоний. Альфа-гемолитические организмы частично лизируют эритроциты, оставляя при этом зеленоватый цвет среды, а гамма-гемолитические организмы вообще не лизируют эритроциты, и среда остается неизменной. В сочетании с историей болезни и морфологией колоний гемолиз, наблюдаемый на кровяном агаре, может помочь микробиологам сделать предположительную идентификацию организма.
Чашка с кровяным агаром, на которой растут альфа-, бета- и гамма-гемолитические организмы (слева направо). Фото: commons.wikimedia.org
В данном случае в образце пациента был обнаружен Streptococcus pyogenes (стрептококк группы А). Хотя для подтверждения идентификации необходимо дополнительное исследование, характерные мелкие колонии с большой зоной бета-гемолиза позволяют предположить наличие S. pyogenes, и знание этого факта помогает микробиологу сориентироваться в дальнейших действиях по идентификации организма. Кроме того, история болезни пациента указывает на некротизирующий фасциит, и рост S. pyogenes выглядит вполне логично.
Пример 2
В микробиологическую лабораторию поступили культуры крови 50-летнего пациента с различными основными, осложненными медицинскими состояниями. На автоматическом приборе для гемокультур через 18 часов инкубации культура крови становится положительной, а при окраске по Граму обнаруживаются грамотрицательные палочки. Кровь наносят на кровяной, МакКонки и шоколадный агары и инкубируют в течение 24 часов. Пока чашки инкубируются, врач звонит в лабораторию и говорит, что он пытается выбрать подходящие антимикробные препараты для этого пациента, и хотел бы как можно скорее узнать, не является ли этот возбудитель Pseudomonas aeruginosa. На следующий день на агаре МакКонки вырастают розовые колонии.

Слева: на агаре МакКонки растет грамотрицательная палочка, ферментирующая лактозу, которая выделяет розовый пигмент. Справа: На агаре МакКонки растет безлактозный ферментер, на котором появляются бесцветные колонии. Фото: Andrea Prinzi.
Объяснение примера 2
Агар МакКонки - пример среды, которая является одновременно дифференциальной и селективной. Присутствие желчных солей, а также кристаллического фиолетового в составе среды предотвращает рост грамположительных организмов. Кроме того, по наличию или отсутствию розового цвета можно отличить грамотрицательные палочки, ферментирующие лактозу, от не ферментирующих лактозу. Когда организм метаболизирует лактозу в среде, окружающий агар становится кислым и активируется нейтральный красный индикатор pH, окрашивая колонии в розовый цвет. Если организм не ферментирует лактозу, колонии остаются бесцветными.
Знать, ферментирует ли организм лактозу или нет, невероятно важно. Например, Pseudomonas aeruginosa не ферментирует лактозу, поэтому чистый рост лактозоферментирующей грамотрицательной палочки в культуре сразу исключает этот организм. В приведенном выше случае врачу можно сказать, что грамотрицательная палочка, растущая в культуре, не является P. aeruginosa, поскольку она ферментирует лактозу на агаре МакКонки. Эта информация помогает врачу выбрать оптимальный курс антимикробного лечения, поскольку Pseudomonas была исключена, и использование антибиотика широкого спектра действия с антипсевдомонадной активностью не требуется.
Пример 3
12-летний пациент поступил в отделение неотложной помощи с сильными спазмами в животе и водянистой диареей в течение нескольких дней. Образец кала собран и отправлен в микробиологическую лабораторию для культивирования.
Объяснение примера 3
Среды, используемые для культивирования кала, различаются в разных лабораториях, но анализ кала - это тот случай, когда полезность дифференциальных сред действительно очевидна. Как правило, человеческий кал содержит большое разнообразие бактерий, и выявление патогенов среди нормальной флоры желудочно-кишечного тракта может быть сложной задачей. Гектоеновый агар - это селективная и дифференциальная среда, которая помогает выделить и отличить Salmonella и Shigella от обычных грамотрицательных организмов, а также предотвращает рост большинства грамположительных организмов. Эта среда содержит 3 углевода, которые дифференцируют характеристики ферментации среди грамотрицательных организмов. В состав среды также входит тиосульфат натрия, который является источником серы. Непатогенная флора желудочно-кишечного тракта ферментирует углеводы и производит колонии ярко-лососевого цвета. Неферментирующие грамотрицательные палочки, такие как Shigella, будут выглядеть как сине-зеленые колонии, а организмы, которые восстанавливают серу до сероводорода, такие как Salmonella, будут производить черные колонии.
Сальмонеллы растут в виде черных колоний на гектоеновом агаре. Фото: commons.wikimedia.org
В приведенном выше случае использование гектоенового агара позволяет микробиологу быстро выявить патогены среди массы нормальной флоры. Возможность макроскопической идентификации патогенных бактерий, таких как Salmonella, экономит время и сокращает трудоемкую работу микробиолога, а также позволяет отобрать колонии для субкультуры и изолировать их для дальнейшей идентификации и тестирования на чувствительность, если это необходимо. Многие другие типы дифференциальных сред также могут обеспечивать выделение патогенных бактерий из образцов кала.
Дифференциальные и селективные среды полезны даже в эпоху молекулярных технологий
С момента появления в 1970-х годах молекулярной диагностики и методов, таких как ПЦР, секвенирование и, совсем недавно, метагеномику, микробиологи и другие специалисты в мире микробной диагностики иногда считают, что эти методы превосходят более традиционные. Хотя конечно есть место для применения возможностей этих постоянно развивающихся и важных инструментов молекулярной диагностики, использование дифференциальных и селективных сред имеет особые преимущества.
Одним из очевидных преимуществ дифференциальных и селективных сред остается стоимость исследований. Молекулярная диагностика требует дорогостоящих реагентов (например, ферментов), специального автоматизированного или полуавтоматизированного оборудования, программного обеспечения, а иногда и специального персонала, обладающего опытом интерпретации результатов. Традиционные среды менее дороги и являются основополагающим стандартом для специалистов клинической микробиологии.
Еще одним преимуществом дифференциальных и селективных сред является то, что они позволяют быстрее получить результаты, особенно в случаях скрининга на ключевые организмы. Кроме того, молекулярные методы (метагеномика) в некоторых случаях могут оказаться не столь чувствительными, как использование дифференциальных и селективных сред. Например, метагеномные праймеры не обладают достаточной чувствительностью для выявления видов, присутствующих в концентрации <105 бактерий на грамм стула.
Традиционное использование дифференциальных и селективных сред также позволяет выделять чистые колонии бактерий, что является строго обязательным для определенных микробиологических методов (например, тестирования на чувствительность, биохимического тестирования и серотипирования). Наконец, молекулярные методы, несмотря на свою способность амплифицировать ДНК, не могут отличить живые бактерии от переходных или погибших бактерий. По всем этим причинам дифференциальные и селективные среды остаются важными инструментами в лаборатории клинической микробиологии.